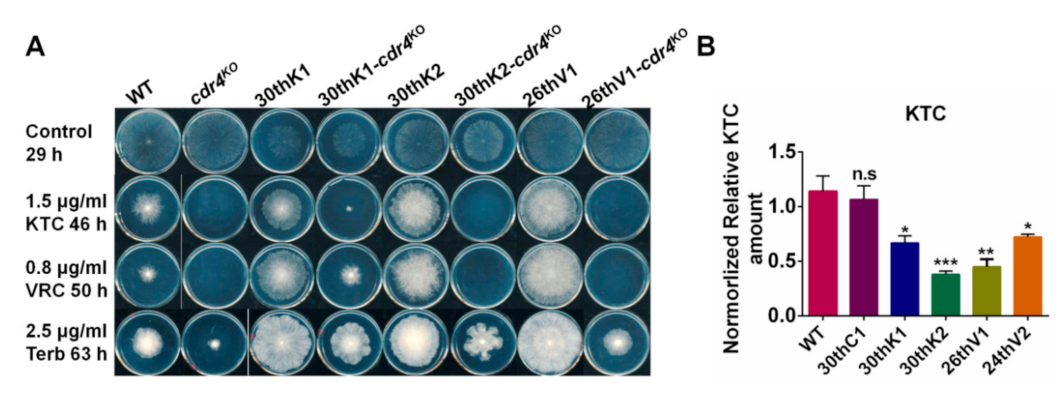
Jof 08 00198 g006 Jof 08 00198 g006

Experimental Evolution of Multidrug Resistance in Neurospora crassa under Antifungal Azole Stress
Abstract
1. Introduction
2. Materials and Methods
2.1. Strains and Cultural Conditions
2.2. Experimental Evolution of Azole Resistance
2.3. Drug Susceptibility Test
2.4. RNA Extraction and Quantitative Real-time RT-PCR (qRT-PCR)
2.5. HPLC-MS Analysis of Sterol Contents and Ketoconazole Accumulation
2.6. The Next-Generation Whole-Genome Resequencing (NGS)
3. Results
3.1. N. crassa Acquired Multidrug Resistance under Azole Stress
3.2. The Multidrug Resistance Developed from Experimental Evolution Is Stably Inherited
3.3. Developmental Processes of Multidrug Resistance in N. crassa Stressed by Different Antifungal Azoles
- Evolutionary direction and trajectory were random. As shown in Figure 2, for each of the tested drugs, evolutionary curves in the four lineages are different and the increased resistance to each drug in four lineages initially appeared at different generations. For example, lineages K1 and K2 evolved from the same strain under KTC stress and developed different levels of resistance for each drug (KTC, VRC, Terb, AmB, PoxB, and MBC). The lineage K1 started to exhibit increased resistance to KTC and VRC at the 25th generation, while the lineage K2 initially showed increased resistance to these azoles at the 15th generation (Figure 2). The lineage K1 rapidly increased Terb resistance after the 20th generation, while Terb resistance in K2 was slightly increased after the 20th generation. For AmB resistance development, the lineage K2 sharply increased AmB resistance after the 5th generation, while AmB resistance in K1 slowly increased from the 5th generation and then rapidly increased after the 15th generation. Both K1 and K2 started to exhibit PoxB resistance at the 20th generation. PoxB resistance in K1 rapidly raised after the 25th generation and reached a peak at the 30th generation, while K2 stably increased PoxB resistance till the 30th generation. MBC resistance in the lineage K1 sharply increased after the 20th generation, while K2 slowly increased MBC resistance from the 15th generation.
- The development of cross resistance to the azoles frequently occurred in N. crassa. In each evolutionary lineage, KTC resistance and VRC resistance almost concurred and increased with the similar developing curve. For example, in the lineage K1, the resistance to both KTC and VRC started to be observed after the 20th generation and quickly increased from the 20th to 25th generation (Figure 2A). A similar case also happened to the evolutionary lineages K2, V1, and V2, although the generation of resistance occurrence varied from one lineage to another.
- The resistances to PoxB and MBC were concurrent to azole resistance. As shown in Figure 2B, the lineage K1 moderately increased resistance to PoxB at the 20th generation, in which KTC resistance in this lineage started to be detected. After the 20th generation, MBC resistance also appeared. In the lineage K2, PoxB resistance and KTC resistance were concurrent after the 15th generation, while MBC resistance occurred after the 20th generation. The resistance to PoxB, MBC, and KTC simultaneously appeared in V1 and V2.
3.4. Transcriptional Changes of Drug Target Genes in the Evolved Strains
3.5. Accumulation of Ergosterol and Sterol Intermediates in the Evolved Strains
3.6. Transcriptional Changes of Transporter Genes for Drug Absorption and Efflux in Evolved Strains
3.7. Overexpression of cdr4 Plays a Vital Role in Azole and Terbinafine Resistance in the Evolved Strains
3.8. Identification of Potential Resistance-Related Genes in Evolved Strains
4. Discussion
Supplementary Materials
Author Contributions
Funding
Institutional Review Board Statement
Informed Consent Statement
Data Availability Statement
Conflicts of Interest
References
- Revie, N.M.; Iyer, K.R.; Robbins, N.; Cowen, L.E. Antifungal drug resistance: Evolution, mechanisms and impact. Curr. Opin. Microbiol. 2018, 45, 70–76. [Google Scholar] [CrossRef] [PubMed]
- Fisher, M.C.; Hawkins, N.J.; Sanglard, D.; Gurr, S.J. Worldwide emergence of resistance to antifungal drugs challenges human health and food security. Science 2018, 360, 739–742. [Google Scholar] [CrossRef]
- Gurr, S.J.; Samalova, M.; Fisher, M. The rise and rise of emerging infectious fungi challenges food security and ecosystem health. Fungal Biol. Rev. 2011, 25, 181–188. [Google Scholar] [CrossRef]
- Sarrocco, S.; Vannacci, G. Preharvest application of beneficial fungi as a strategy to prevent postharvest mycotoxin contamination: A review. Crop Prot. 2018, 110, 160–170. [Google Scholar] [CrossRef]
- Scheele, B.C.; Pasmans, F.; Skerratt, L.F.; Berger, L.; Martel, A.; Beukema, W.; Acevedo, A.A.; Burrowes, P.A.; Carvalho, T.; Catenazzi, A.; et al. Amphibian fungal panzootic causes catastrophic and ongoing loss of biodiversity. Science 2019, 363, 1459–1463. [Google Scholar] [CrossRef] [PubMed]
- Fisher, M.C.; Henk, D.A.; Briggs, C.J.; Brownstein, J.S.; Madoff, L.C.; McCraw, S.L.; Gurr, S.J. Emerging fungal threats to animal, plant and ecosystem health. Nature 2012, 484, 186–194. [Google Scholar] [CrossRef]
- Shapiro, R.; Robbins, N.; Cowen, L.E. Regulatory Circuitry Governing Fungal Development, Drug Resistance, and Disease. Microbiol. Mol. Biol. Rev. 2011, 75, 213–267. [Google Scholar] [CrossRef]
- Campoy, S.; Adrio, J.L. Antifungals. Biochem. Pharmacol. 2017, 133, 86–96. [Google Scholar] [CrossRef]
- Isono, K.; Asahi, K.; Suzuki, S. Polyoxins, antifungal antibiotics. XIII. Structure of polyoxins. J. Am. Chem. Soc. 1969, 91, 7490–7505. [Google Scholar] [CrossRef]
- Suzuki, S.; Isono, K.; Nagatsu, J.; Mizutani, T.; Kawashima, Y.; Mizuno, T. A New Antibiotic, Polyoxin A. J. Antibiot. 1965, 18, 131. [Google Scholar] [CrossRef]
- Isono, K. Nucleoside antibiotics: Structure, biological activity, and biosynthesis. J. Antibiot. 1988, 41, 1711–1739. [Google Scholar] [CrossRef] [PubMed]
- Chen, Y.; Zhou, M.-G. Characterization of Fusarium graminearum isolates resistant to both carbendazim and a new fun-gicide JS399–19. Phytopathology 2009, 99, 441–446. [Google Scholar] [CrossRef] [PubMed]
- Zhu, Z.-Q.; Zhou, F.; Li, J.-L.; Zhu, F.-X.; Ma, H.-J. Carbendazim resistance in field isolates of Sclerotinia sclerotiorum in China and its management. Crop Prot. 2016, 81, 115–121. [Google Scholar] [CrossRef]
- Gulshan, K.; Moye-Rowley, W.S. Multidrug Resistance in Fungi. Eukaryot. Cell 2007, 6, 1933–1942. [Google Scholar] [CrossRef] [PubMed]
- Berman, J.; Krysan, D.J. Drug resistance and tolerance in fungi. Nature Reviews Microbiology 2020, 18, 319–331. [Google Scholar] [CrossRef] [PubMed]
- Barber, A.E.; Weber, M.; Kaerger, K.; Linde, J.; Gölz, H.; Duerschmied, D.; Markert, A.; Guthke, R.; Walther, G.; Kurzai, O. Comparative Genomics of Serial Candida glabrata Isolates and the Rapid Acquisition of Echinocandin Resistance during Therapy. Antimicrob. Agents Chemother. 2019, 63, 01628. [Google Scholar] [CrossRef]
- Arendrup, M.C.; Patterson, T.F. Multidrug-Resistant Candida: Epidemiology, Molecular Mechanisms, and Treatment. J. Infect. Dis. 2017, 216, S445–S451. [Google Scholar] [CrossRef]
- Ben-Ami, R.; Berman, J.; Novikov, A.; Bash, E.; Shachor-Meyouhas, Y.; Zakin, S.; Maor, Y.; Tarabia, J.; Schechner, V.; Adler, A.; et al. Multidrug-ResistantCandida haemuloniiandC. auris, Tel Aviv, Israel. Emerg. Infect. Dis. 2017, 23, 195–203. [Google Scholar] [CrossRef]
- Lockhart, S.R.; Etienne, K.A.; Snigdha, V.; Joveria, F.; Anuradha, C.; Govender, N.P.; Lopes, C.A.; Belinda, C.; Cuomo, C.A.; Desjardins, C.A. Simultaneous emergence of multidrug-resistant Candida auris on 3 continents confirmed by whole-genome sequencing and epidemiological analyses. Clin. Infect. Dis. 2017, 67, 987. [Google Scholar] [CrossRef]
- Meis, J.F.; Chowdhary, A.; Rhodes, J.L.; Fisher, M.C.; Verweij, P.E. Clinical implications of globally emerging azole resistance in Aspergillus fumigatus. Philos. Trans. R. Soc. B Biol. Sci. 2016, 371, 20150460. [Google Scholar] [CrossRef]
- Arikan-Akdagli, S.; Ghannoum, M.; Meis, J.F. Antifungal Resistance: Specific Focus on Multidrug Resistance in Candida auris and Secondary Azole Resistance in Aspergillus fumigatus. J. Fungi 2018, 4, 129. [Google Scholar] [CrossRef] [PubMed]
- Yona, A.H.; Frumkin, I.; Pilpel, Y. A Relay Race on the Evolutionary Adaptation Spectrum. Cell 2015, 163, 549–559. [Google Scholar] [CrossRef] [PubMed]
- Lewis, K. Multidrug Tolerance of Biofilms and Persister Cells. In Current Topics in Microbiology and Immunology; Romeo, T., Ed.; Springer: Berlin/Heidelberg, Germany, 2008; Volume 322, pp. 107–131. [Google Scholar] [CrossRef]
- Fisher, K.J.; Lang, G.I. Experimental evolution in fungi: An untapped resource. Fungal Genet. Biol. 2016, 94, 88–94. [Google Scholar] [CrossRef] [PubMed]
- Baym, M.; Lieberman, T.D.; Kelsic, E.D.; Chait, R.; Gross, R.; Yelin, I.; Kishony, R. Spatiotemporal microbial evolution on antibiotic landscapes. Science 2016, 353, 1147–1151. [Google Scholar] [CrossRef]
- Cowen, L.E.; Sanglard, D.; Calabrese, D.; Sirjusingh, C.; Anderson, J.B.; Kohn, L.M. Evolution of drug resistance in ex-perimental populations of Candida albicans. J. Bacteriol. 2000, 182, 1515–1522. [Google Scholar] [CrossRef]
- Wei, X.; Chen, P.; Gao, R.; Li, Y.; Zhang, A.-X.; Liu, F.; Lu, L. Screening and Characterization of a Non- cyp51A Mutation in an Aspergillus fumigatus cox10 Strain Conferring Azole Resistance. Antimicrob. Agents Chemother. 2017, 61, 14. [Google Scholar] [CrossRef]
- Honda, S.; Eusebio-Cope, A.; Miyashita, S.; Yokoyama, A.; Aulia, A.; Shahi, S.; Kondo, H.; Suzuki, N. Establishment of Neurospora crassa as a model organism for fungal virology. Nat. Commun. 2020, 11, 1–13. [Google Scholar] [CrossRef]
- Yin, Y.; Zhang, H.; Zhang, Y.; Hu, C.; Sun, X.; Liu, W.; Li, S. Fungal Zn(II) 2 Cys 6 Transcription Factor ADS-1 Regulates Drug Efflux and Ergosterol Metabolism under Antifungal Azole Stress. Antimicrob. Agents Chemother. 2021, 65, 01316–01320. [Google Scholar] [CrossRef]
- Wang, K.; Zhang, Z.; Chen, X.; Sun, X.; Jin, C.; Liu, H.; Li, S. Transcription Factor ADS-4 Regulates Adaptive Responses and Resistance to Antifungal Azole Stress. Antimicrob. Agents Chemother. 2015, 59, 5396–5404. [Google Scholar] [CrossRef]
- Chen, X.; Xue, W.; Zhou, J.; Zhang, Z.; Wei, S.; Liu, X.; Sun, X.; Wang, W.; Li, S. De-repression of CSP-1 activates adaptive responses to antifungal azoles. Sci. Rep. 2016, 6, 19447. [Google Scholar] [CrossRef]
- Xue, W.; Yin, Y.; Ismail, F.; Hu, C.; Zhou, M.; Cao, X.; Li, S.; Sun, X. Transcription factor CCG-8 plays a pivotal role in azole adaptive responses of Neurospora crassa by regulating intracellular azole accumulation. Curr. Genet. 2019, 65, 735–745. [Google Scholar] [CrossRef] [PubMed]
- Hu, C.; Zhou, M.; Wang, W.; Sun, X.; Yarden, O.; Li, S. Abnormal Ergosterol Biosynthesis Activates Transcriptional Responses to Antifungal Azoles. Front. Microbiol. 2018, 9, 9. [Google Scholar] [CrossRef] [PubMed]
- Margolin, B.; Freitag, M.; Selker, E. Improved plasmids for gene targeting at the his-3 locus of Neurospora crassa by electroporation. Fungal Genet. Newsletter 1997, 44, 34–36. [Google Scholar] [CrossRef]
- Schimoler-O’Rourke, R.; Renault, S.; Mo, W.; Selitrennikoff, C.P. Neurospora crassa FKS Protein Binds to the (1,3)?-Glucan Synthase Substrate, UDP-Glucose. Curr. Microbiol. 2003, 46, 408–412. [Google Scholar] [CrossRef]
- Sun, X.; Wang, W.; Wang, K.; Yu, X.; Liu, J.; Zhou, F.; Xie, B.; Li, S. Sterol C-22 Desaturase ERG5 Mediates the Sensitivity to Antifungal Azoles in Neurospora crassa and Fusarium verticillioides. Front. Microbiol. 2013, 4, 127. [Google Scholar] [CrossRef]
- Lee, S.B.; Milgroom, M.G.; Taylor, J.W. A rapid, high yield mini-prep method for isolation of total genomic DNA from fungi. Fungal Genet. Rep. 1988, 35, 23. [Google Scholar] [CrossRef]
- Alcazar-Fuoli, L.; Mellado, E. Ergosterol biosynthesis in Aspergillus fumigatus: Its relevance as an antifungal target and role in antifungal drug resistance. Front. Microbiol. 2013, 3, 439. [Google Scholar] [CrossRef]
- Zhang, Y.; Zhang, Z.; Zhang, X.; Zhang, H.; Sun, X.; Hu, C.; Li, S. CDR4 is the major contributor to azole resistance among four Pdr5p-like ABC transporters in Neurospora crassa. Fungal Biol. 2012, 116, 848–854. [Google Scholar] [CrossRef]
- Song, T.-T.; Ying, S.-H.; Feng, M.-G. High resistance of Isaria fumosorosea to carbendazim arises from the overexpression of an ATP-binding cassette transporter (ifT1) rather than tubulin mutation. J. Appl. Microbiol. 2012, 112, 175–184. [Google Scholar] [CrossRef]
- Kano, R.; Hsiao, Y.-H.; Han, H.S.; Chen, C.; Hasegawa, A.; Kamata, H. Resistance Mechanism in a Terbinafine-Resistant Strain of Microsporum canis. Mycopathologia 2018, 183, 623–627. [Google Scholar] [CrossRef]
- Fachin, A.L.; Ferreira-Nozawa, M.S.; Maccheroni, W.; Martinez-Rossi, N.M. Role of the ABC transporter TruMDR2 in terbinafine, 4-nitroquinoline N-oxide and ethidium bromide susceptibility in Trichophyton rubrum. J. Med. Microbiol. 2006, 55, 1093–1099. [Google Scholar] [CrossRef] [PubMed]
- Nakajima, M.; Suzuki, J.; Hosaka, T.; Hibi, T.; Akutsu, K. Functional Analysis of an ATP-Binding Cassette Transporter Gene in Botrytis cinerea by Gene Disruption. J. Gen. Plant Pathol. 2001, 67, 212–214. [Google Scholar] [CrossRef]
- Mehta, R.J.; Kingsbury, W.D.; Valenta, J.; Actor, P. Anti-Candida activity of polyoxin: Example of peptide transport in yeasts. Antimicrob. Agents Chemother. 1984, 25, 373–374. [Google Scholar] [CrossRef] [PubMed]
- Schielmann, M.; Szweda, P.; Gucwa, K.; Kawczyński, M.; Milewska, M.J.; Martynow, D.; Morschhäuser, J.; Milewski, S. Transport Deficiency Is the Molecular Basis of Candida albicans Resistance to Antifungal Oligopeptides. Front. Microbiol. 2017, 8, 2154. [Google Scholar] [CrossRef]
- Davies, M.B. Peptide Uptake in Candida albicans. Microbiology 1980, 121, 181–186. [Google Scholar] [CrossRef]
- Papp, C.; Bohner, F.; Kocsis, K.; Varga, M.; Szekeres, A.; Bodai, L.; Willis, J.R.; Gabaldón, T.; Tóth, R.; Nosanchuk, J.D.; et al. Triazole Evolution of Candida parapsilosis Results in Cross-Resistance to Other Antifungal Drugs, Influences Stress Responses, and Alters Virulence in an Antifungal Drug-Dependent Manner. mSphere 2020, 5, e00821-20. [Google Scholar] [CrossRef]
- Hughes, D.; Andersson, D.I. Evolutionary consequences of drug resistance: Shared principles across diverse targets and organisms. Nat. Rev. Genet. 2015, 16, 459–471. [Google Scholar] [CrossRef]
- Pringle, A.; Taylor, J.W. The fitness of filamentous fungi. Trends Microbiol. 2002, 10, 474–481. [Google Scholar] [CrossRef]
- Farquhar, K.S.; Koohi, S.R.; Charlebois, D.A. Does transcriptional heterogeneity facilitate the development of genetic drug resistance? BioEssays 2021, 43, 2100043. [Google Scholar] [CrossRef]
- Fujimura, M.; Oeda, K.; Inoue, H.; Kato, T. A single amino-acid substitution in the beta-tubulin gene of Neurospora confers both carbendazim resistance and diethofencarb sensitivity. Curr. Genet. 1992, 21, 399–404. [Google Scholar] [CrossRef]
- Young, L.Y.; Hull, C.M.; Heitman, J. Disruption of Ergosterol Biosynthesis Confers Resistance to Amphotericin B in Candida lusitaniae. Antimicrob. Agents Chemother. 2003, 47, 2717–2724. [Google Scholar] [CrossRef] [PubMed]
- Posch, W.; Blatzer, M.; Wilflingseder, D.; Lass-Flörl, C. Aspergillus terreus: Novel lessons learned on amphotericin B resistance. Med. Mycol. 2018, 56, S73–S82. [Google Scholar] [CrossRef] [PubMed]

| Strains | Source | Genotype | MICKTC 1 (μg/mL) | MICVRC 2 (μg/mL) |
|---|---|---|---|---|
| Wild type (FGSC#4200) | FGSC (Fungal Genetics Stock Center) | Prototrophic | 3.65 | 1.4 |
| 30thC1 | this study | Prototrophic | 3.65 | 1.4 |
| 30thC2 | this study | Prototrophic | 3.65 | 1.4 |
| 30thK1 | this study | Prototrophic | 9 | 4.8 |
| 30thK2 | this study | Prototrophic | 10.8 | 4.6 |
| 26thV1 | this study | Prototrophic | 11.8 | 6.4 |
| 24thV2 | this study | Prototrophic | 20 | 9.5 |
| cdr4KO (FGSC#11238) | FGSC | cdr4 knockout | ||
| cdr4OE | this study | cdr4 overexpression | ||
| 30thK1-cdr4KO | this study | cdr4 knockout | ||
| 30thK2-cdr4KO | this study | cdr4 knockout | ||
| 26thV1-cdr4KO | this study | cdr4 knockout |
| Terb Resistance | Azole Resistance | AmB Resistance | PoxB Resistance | ||||||
|---|---|---|---|---|---|---|---|---|---|
| Target | Transporter | Others | Target | Transporter | Others | Others | Transporter | Others | |
| 30thK1 | erg1 (SUR) 1 | cdr4 (UR) 2 | mutations in NCU02058, NCU02052, NCU02060, NCU02051, NCU02052, NCU02026, NCU01947 | erg11 (SUR) | cdr4 (UR) | mutations in NCU02058, NCU02060, NCU02055, NCU02051, NCU02026, NCU02012, NCU01993 NCU03246 | transcriptional changes in cat-1/ 3/ 4; mutations in NCU02058 | atrf-2 (UR); DR 3: NCU03171, mfs-9, mfs-8, NCU08397 and opt-1 | |
| 30thK2 | cdr4 (UR) | mutations in NCU09308, NCU02051, NCU02026, NCU01997 | cdr4 (UR) | mutations in NCU02548, NCU03491, NCU02051, NCU02026, NCU02012, NCU01993 | transcriptional changes in cat-1/ 3/ 4 | atrf-2 (UR); DR: mfs-8, opt-1 and NCU08397 | |||
| 26thV1 | cdr4 (UR) | mutations in NCU02051, NCU02867 | cdr4 (UR) | mutations in NCU02548, NCU03491, NCU02051, NCU01967, NCU02867 | mutations in NCU02548, NCU03491, NCU02051, NCU01967, NCU02867 | atrf-2 (UR); DR: mfs-8, NCU08397 and opt-1 | mutations in NCU01967 | ||
| 24thV2 | erg1 (SUR) | cdr4 (UR) | erg11 (UR) | cdr4 (UR) | transcriptional change in cat-1/ 3/ 4 | DR: NCU03171, mfs-9, mfs-8, opt-1 and NCU08397 | |||
Publisher’s Note: MDPI stays neutral with regard to jurisdictional claims in published maps and institutional affiliations. |
© 2022 by the authors. Licensee MDPI, Basel, Switzerland. This article is an open access article distributed under the terms and conditions of the Creative Commons Attribution (CC BY) license (https://creativecommons.org/licenses/by/4.0/).
Share and Cite
Zhou, M.; Hu, C.; Yin, Y.; Wang, J.; Ye, S.; Yu, Y.; Sun, X.; Li, S. Experimental Evolution of Multidrug Resistance in Neurospora crassa under Antifungal Azole Stress. J. Fungi 2022, 8, 198. https://doi.org/10.3390/jof8020198
Zhou M, Hu C, Yin Y, Wang J, Ye S, Yu Y, Sun X, Li S. Experimental Evolution of Multidrug Resistance in Neurospora crassa under Antifungal Azole Stress. Journal of Fungi. 2022; 8(2):198. https://doi.org/10.3390/jof8020198
Chicago/Turabian StyleZhou, Mi, Chengcheng Hu, Yajing Yin, Jingji Wang, Shuting Ye, Yifa Yu, Xianyun Sun, and Shaojie Li. 2022. "Experimental Evolution of Multidrug Resistance in Neurospora crassa under Antifungal Azole Stress" Journal of Fungi 8, no. 2: 198. https://doi.org/10.3390/jof8020198
APA StyleZhou, M., Hu, C., Yin, Y., Wang, J., Ye, S., Yu, Y., Sun, X., & Li, S. (2022). Experimental Evolution of Multidrug Resistance in Neurospora crassa under Antifungal Azole Stress. Journal of Fungi, 8(2), 198. https://doi.org/10.3390/jof8020198

